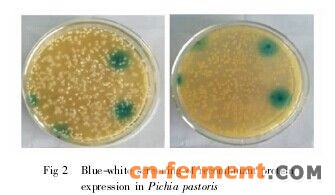
3

方法/步骤
-
首先,在YPD平板上划线毕赤酵母X33菌株,在28-30摄氏度培养两天,以得到分散的单菌落。
-
然后,挑取酵母单菌落,接种至含有10mlYPD培养基的100ml三角瓶中,在30摄氏度250-300r/min培养过夜至饱和。

-
然后,取300微升的培养物接种至含有150ml新鲜YPD培养基的500ml三角摇瓶中,在28-30摄氏度205-300r/min培养过夜,约十小时至OD600达到1.3-1.5.

-
然后,将细胞培养物于4摄氏度1500g离心五分钟,弃上清液,用150ml预冷的无菌水悬浮菌体沉淀。

-
然后,在4摄氏度1500g离心五分钟,弃上清液后用75ml的冰预冷的无菌水将菌体沉淀重悬。

-
然后,在在4摄氏度1500g离心五分钟,弃上清液后用10ml的冰预冷的1mol/l的山梨醇溶液将菌体沉淀重悬。
-
最后,在4摄氏度1500g离心五分钟,弃上清液后用300微升的冰预冷的1mol/l的山梨醇溶液将菌体沉淀重悬,其终体积约为500微升,移至0.5ml的离心管中,进行冰浴待转化。




